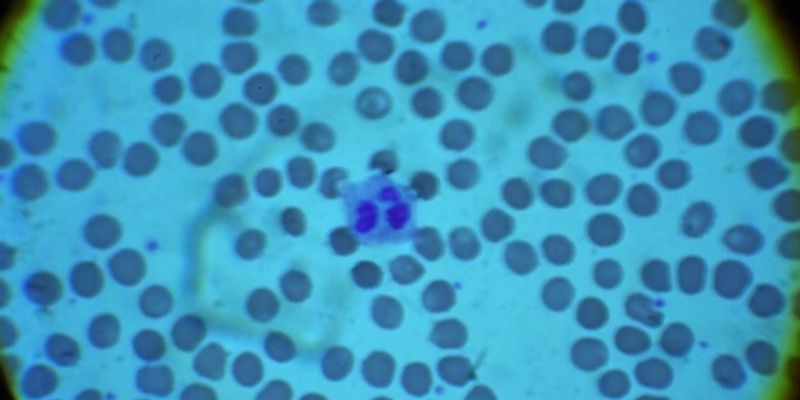

Special Stains
Special Stains refers to any staining technique other than haematoxylin and eosin (H&E) that are applied for a single purpose. It gives information presence of certain class of molecules, their localization and the number of molecules present.
What's Popular in Special Stains
-
JAN 09, 2024TechnologyIn a groundbreaking leap forward for breast cancer surgery, the MAGTOTAL trial has unveiled a promising alternative to t ...Written By: Greta AnneDEC 19, 2023Cell & Molecular BiologyScientists have created a spatial atlas of the incredible process of human limb development, including processes that in ...Written By: Carmen LeitchMAY 20, 2023TechnologyCan bacteria be engineered to monitor the environment and other applications? This is what a recent study published in N ...Written By: Laurence Tognetti, MScAPR 20, 2022CancerRecent advances in immune checkpoint inhibitors (ICI) have led to significant clinical benefits for patients with variou ...Written By: Katie KokolusOCT 28, 2021Cell & Molecular BiologyProtein production is essential for life; cells use DNA to transcribe active genes into RNA sequences, and ribosomes tra ...Written By: Carmen Leitch
JAN 09, 2024
Technology
In a groundbreaking leap forward for breast cancer surgery, the MAGTOTAL trial has unveiled a promising alternative to t
...
Written By:
Greta Anne
DEC 19, 2023
Cell & Molecular Biology
Scientists have created a spatial atlas of the incredible process of human limb development, including processes that in
...
Written By:
Carmen Leitch
MAY 20, 2023
Technology
Can bacteria be engineered to monitor the environment and other applications? This is what a recent study published in N
...
Written By:
Laurence Tognetti, MSc
APR 20, 2022
Cancer
Recent advances in immune checkpoint inhibitors (ICI) have led to significant clinical benefits for patients with variou
...
Written By:
Katie Kokolus
OCT 28, 2021
Cell & Molecular Biology
Protein production is essential for life; cells use DNA to transcribe active genes into RNA sequences, and ribosomes tra
...
Written By:
Carmen Leitch
JUN 28, 2021
Cell & Molecular Biology
Though originally thought of as strictly a waste disposal system, extracellular vesicles (EVs) have been shown to have m
...
APR 28, 2021
Microbiology
The methods of pathogen/pathology determination require the generation of Hazardous Wastes. Some processes are mostly au
...
Written By:
Scott Leard, Leard Environmental Services, Inc.
AUG 03, 2020
Cancer
Diagnostics is one of the essential tools in a physician’s toolkit. A good diagnostic test can identify whether a
...
Written By:
Jasper Cantrell
MAR 17, 2020
Genetics & Genomics
Researchers screened thousands of target molecules to find the most effective targets, and have made their data openly a
...
Written By:
Carmen Leitch
-
OCT 26, 2023 | 10:00 AMClinical laboratories rely on slide staining to clearly analyze components of patient samples and facilitate accurate diagnosis. While automated staining in itself is a great advancement ove...NOV 17, 2022 | 8:00 AMDate: November 17, 2022 Time: 8:00am (PST), 11:00am (EST), 5:00pm (CET) Have you ever wished you had access to the technical specialist who wrote the book ......NOV 17, 2022 | 7:00 AMDate: November 17, 2022 Time: 7:00am (PST), 10:00am (EST), 4:00pm (CET) In order to truly understand cell biology, researchers need easy-to-use tools that preserve the natural complexity of...AUG 31, 2022 | 8:00 AMDate: August 31, 2022 Time: 8:00am (PDT), 11:00am (EDT), 5:00pm (CEST) Antibodies are specialized proteins generated by an immune system in response to disease and infection. The staining ge...MAR 24, 2022 | 10:00 AMDate: March 24, 2022 Time: 10:00am (PDT), 1:00pm (EDT), 7:00pm (CET) Easy-to-use AI-based deep learning is now integrated as the standard analysis methodology in our best-in-class analysis s...
OCT 26, 2023 | 10:00 AM
Clinical laboratories rely on slide staining to clearly analyze components of patient samples and facilitate accurate diagnosis. While automated staining in itself is a great advancement ove...
NOV 17, 2022 | 8:00 AM
Date: November 17, 2022 Time: 8:00am (PST), 11:00am (EST), 5:00pm (CET) Have you ever wished you had access to the technical specialist who wrote the book ......
NOV 17, 2022 | 7:00 AM
Date: November 17, 2022 Time: 7:00am (PST), 10:00am (EST), 4:00pm (CET) In order to truly understand cell biology, researchers need easy-to-use tools that preserve the natural complexity of...
AUG 31, 2022 | 8:00 AM
Date: August 31, 2022 Time: 8:00am (PDT), 11:00am (EDT), 5:00pm (CEST) Antibodies are specialized proteins generated by an immune system in response to disease and infection. The staining ge...
MAR 24, 2022 | 10:00 AM
Date: March 24, 2022 Time: 10:00am (PDT), 1:00pm (EDT), 7:00pm (CET) Easy-to-use AI-based deep learning is now integrated as the standard analysis methodology in our best-in-class analysis s...
DEC 01, 2021 | 9:00 AM
Date: December 1, 2021 Time: 9:00am (PDT), 12:00pm (EDT) The enumeration and analysis of blood cells with automated haematology analysers have significantly improved in recent years due to a...
JUN 16, 2021 | 8:00 AM
Date: June 16, 2021 Time: 8:00am PDT The MACSima™ Imaging Platform is the only complete solution for ultrahigh-content imaging of hundreds of markers, allowing you to understand the tu...
Proximity Ligation Assay (PLA), is a powerful technique for demonstrating the presence of 2 unique targets in direct proximity of each other in tissue sections. It allows visualization of in...
MAR 24, 2021 | 7:00 AM
Date: March 24, 2021 Time: 7:00am (PST), 10:00am (EST), 3:00pm (CET) Multiplex immunofluorescence IHC is a powerful technique to address the increasing research needs in immuno-oncology t...
-
OCT 20, 2021 | 7:00 AM PDTA good quality process lays the foundations for quality research results. Leica Biosystems welcomes the global Life Science community to discuss the importance of focusing on “why qual...FEB 27, 2019 | 6:00 AM PSTLabroots and the Drug Discovery planning committee are pleased to announce its 2nd annual event in the Drug Discovery Virtual Event Series....NOV 14, 2018Register for free to attend the 6th annual Gibco™ 24 Hours of Stem Cells™ virtual event, the largest global virtual stem cell event taking place around the world on November 15, 2...APR 10, 2017 | 6:00 AM PDTThe Protein and cell analysis education site is a free-access destination where you can learn more about applications and techniques related to protein gel chemistries, western detection, mas...JAN 25, 2017 | 5:00 AM PSTThe Abcam virtual exhibition is temporarily closed. It will re-open shortly. Please check back October 25th. All webinars will be available for viewing at that time.Get the su...
OCT 20, 2021
| 7:00 AM PDT
A good quality process lays the foundations for quality research results. Leica Biosystems welcomes the global Life Science community to discuss the importance of focusing on “why qual...
FEB 27, 2019
| 6:00 AM PST
Labroots and the Drug Discovery planning committee are pleased to announce its 2nd annual event in the Drug Discovery Virtual Event Series....
NOV 14, 2018
Register for free to attend the 6th annual Gibco™ 24 Hours of Stem Cells™ virtual event, the largest global virtual stem cell event taking place around the world on November 15, 2...
APR 10, 2017
| 6:00 AM PDT
The Protein and cell analysis education site is a free-access destination where you can learn more about applications and techniques related to protein gel chemistries, western detection, mas...
JAN 25, 2017
| 5:00 AM PST
The Abcam virtual exhibition is temporarily closed. It will re-open shortly. Please check back October 25th. All webinars will be available for viewing at that time.Get the su...
SEP 14, 2016
| 6:30 AM PDT
An industry leader in delivering instrument systems, reagents, and services to life science researchers,Beckman Coulter Life Sciences helps enable new discoveries in biology-based research...
SEP 07, 2016
| 6:00 AM PDT
The 2nd Annual Event in the Microbiology & Immunology Virtual Event Series is now On Demand! This premier venue discusses the latest research on microscopic organisms and their interacti...
APR 06, 2016
| 6:00 AM PDT
This event is now apart of the Genetics Week Virtual Event Series. The 1st Annual Event in the Molecular Diagnostics Virtual Event Series is now On Demand! This premiere venue is for scienti...
SEP 02, 2015
| 6:00 AM PDT
Welcome to Labroots 1st Annual Event in the Microbiology Virtual Event Series free online conference! Microbiology is the study of microscopic organisms...